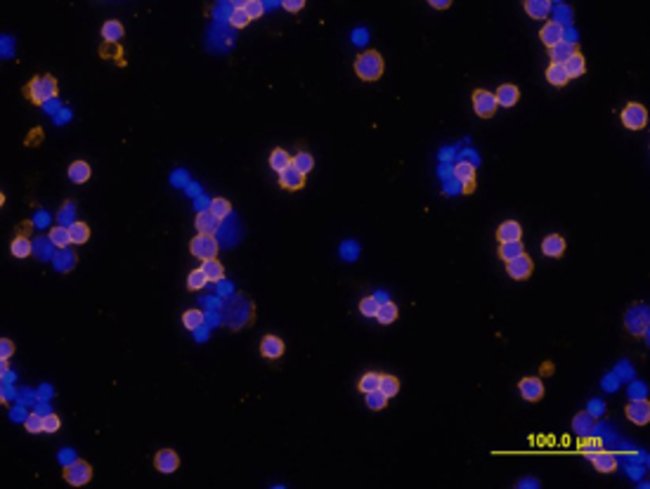

B220/Cd45r Rat Anti-Mouse, Clone: Ra3-6b2, Rat Monoclonal Antibody, Each
$ 910.72
|
|
Details:
B220/CD45R Monoclonal antibody MAB1217 Specifically detects B220/CD45R in Mouse samples. It is validated for Flow Cytometry, Immunocytochemistry, Immunoprecipitatio
Additional Information
| SKU | 10143015 |
|---|---|
| UOM | Each |
| UNSPSC | 12352200 |
| Manufacturer Part Number | MAB1217 |
